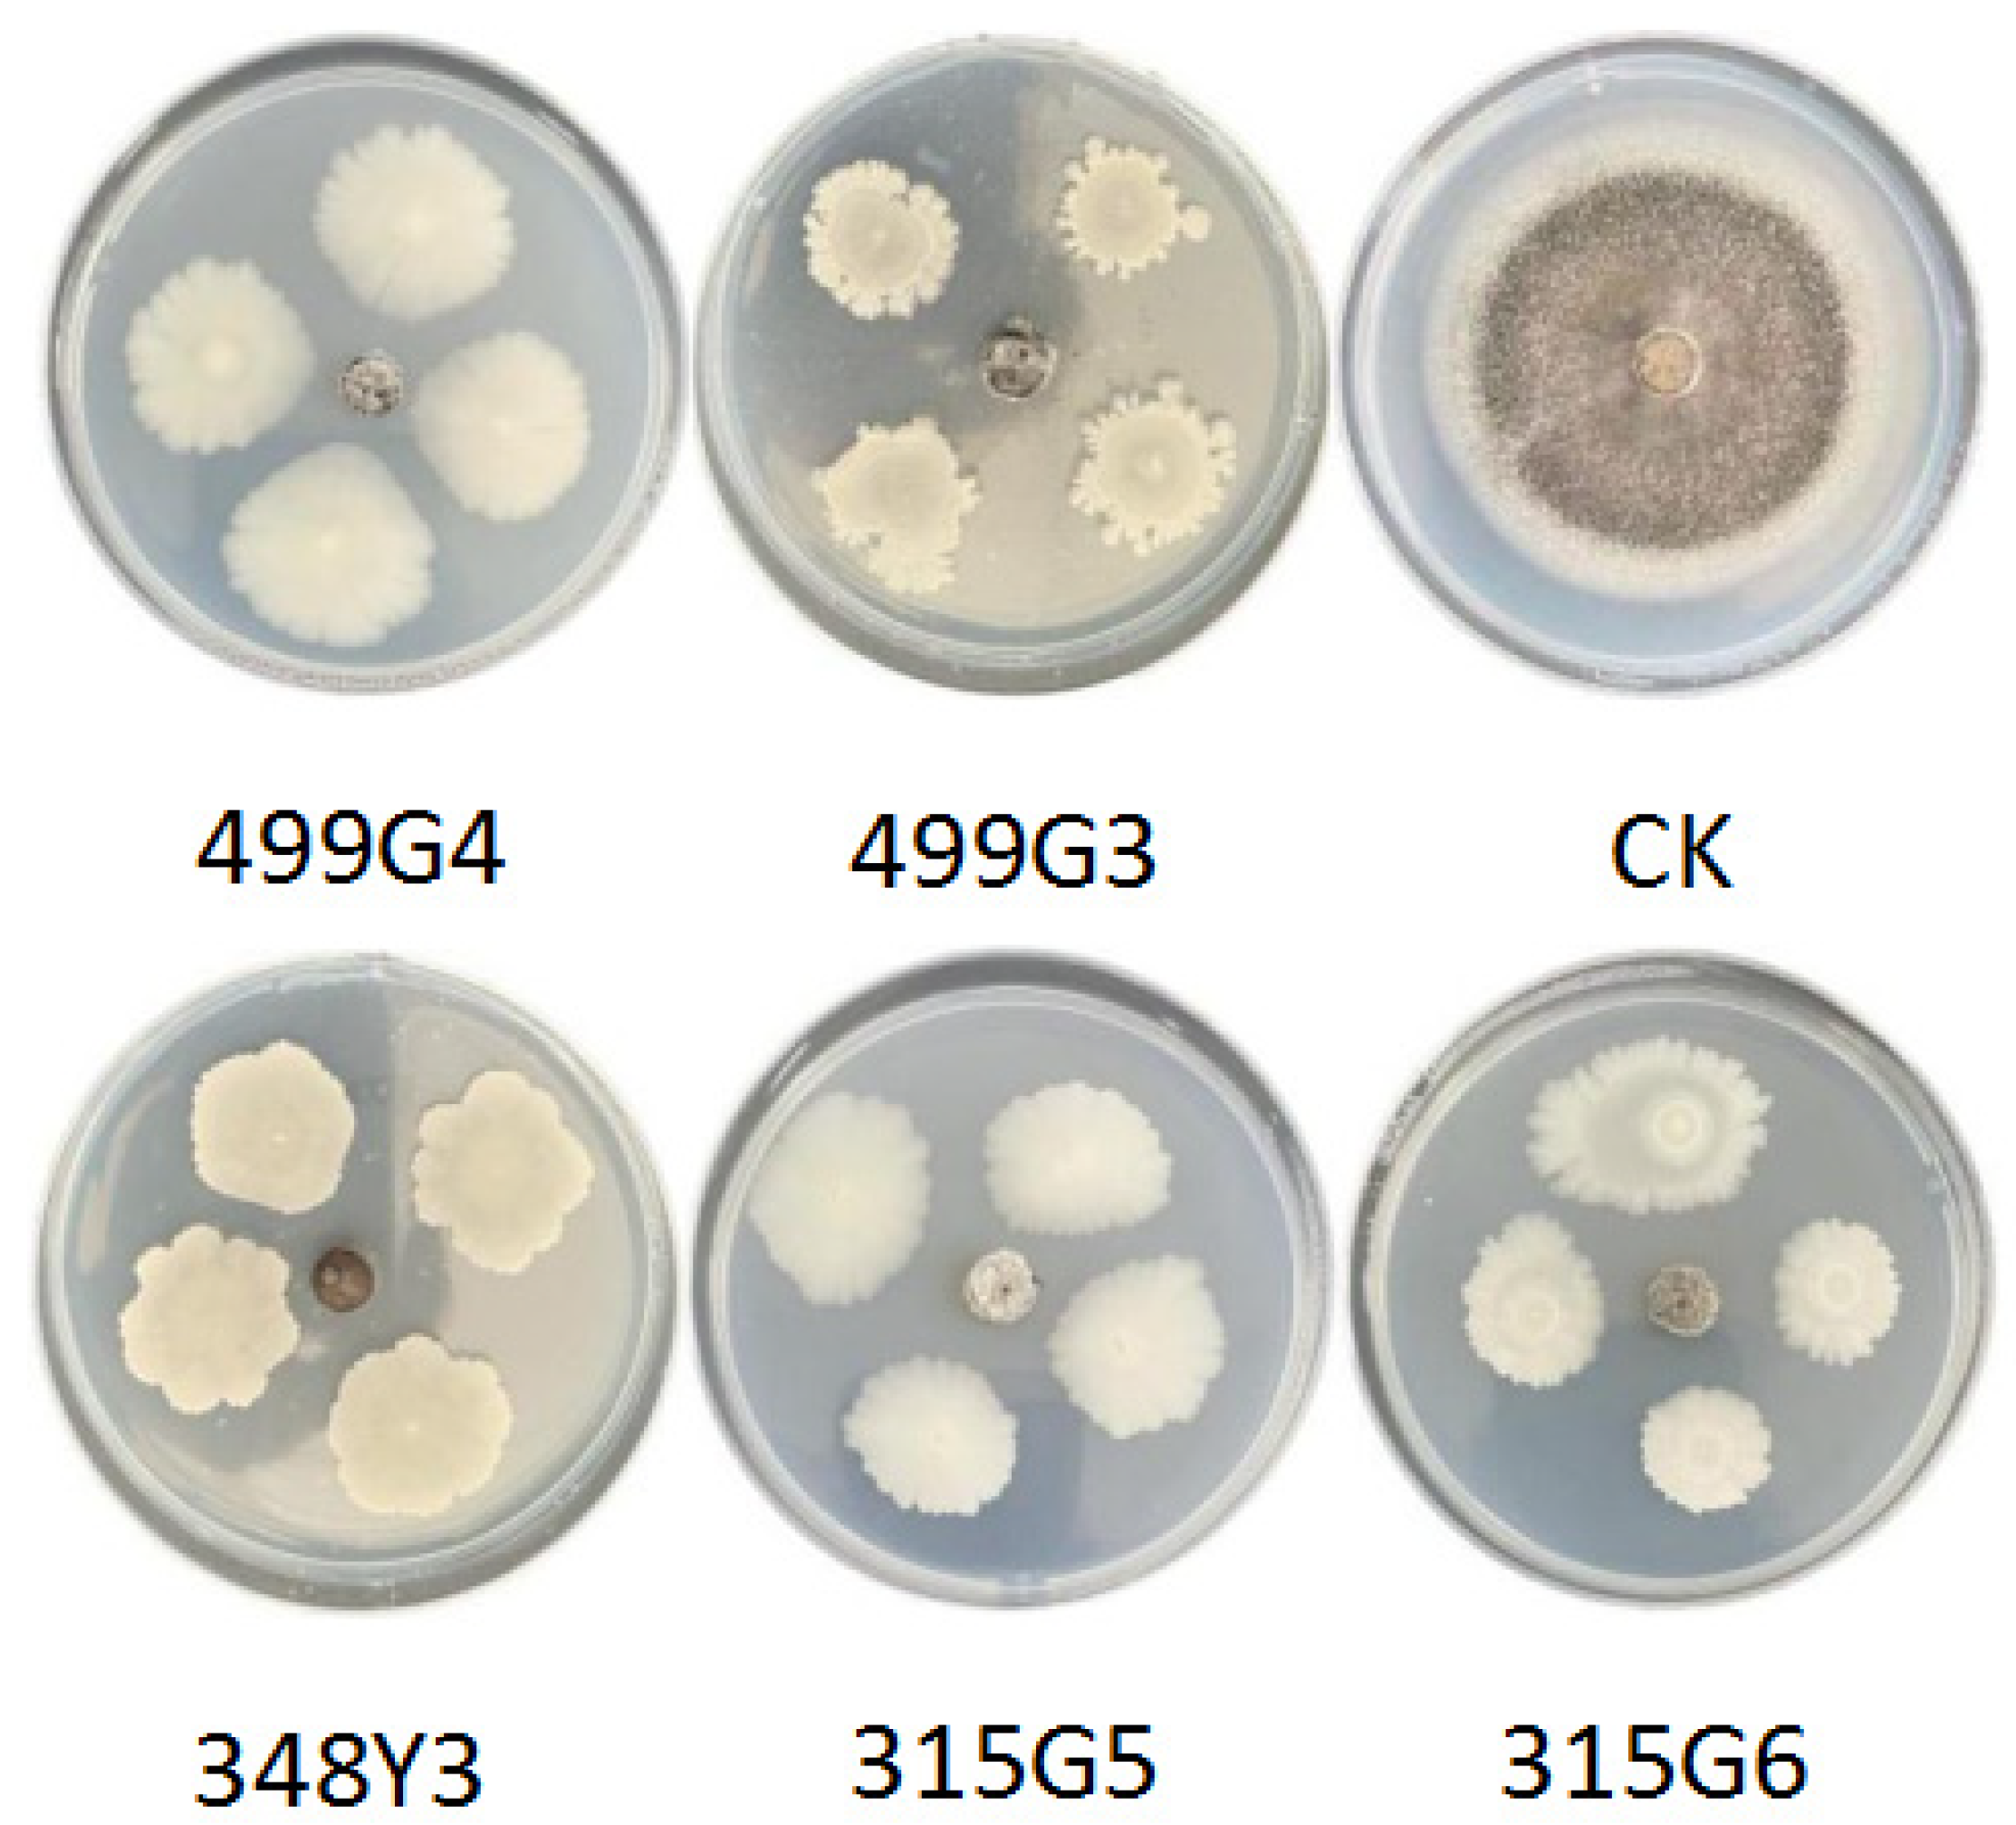
Microorganisms 10 01468 g002

Culturable Screening of Plant Growth-Promoting and Biocontrol Bacteria in the Rhizosphere and Phyllosphere of Wild Rice
Abstract
:1. Introduction
2. Materials and Methods
2.1. Experiment Material
2.2. Screening of Culturable Bacteria in Rhizosphere and Phyllosphere
2.3. Identification of Strains
2.4. Assessment of Antagonistic Effect
2.5. Evaluation of Bacteria Growth-Promoting Activity
2.6. Pot Experiment
3. Results
3.1. Screening and Identification of Culturable Bacteria in the Rhizosphere and Phyllosphere of Rice
3.2. Assessment of Antagonistic Effect
3.3. Evaluation of Bacteria Growth-Promoting Activity
3.4. Results in Pot Experiment
3.5. Effect of Bacterial Application on Rice Resistance to Magnaporthe grisea
4. Discussion
4.1. Screening and Identification of Biocontrol Bacteria
4.2. Growth-Promoting Effect of Biocontrol Bacteria
4.3. Biocontrol Effect of Biocontrol Bacteria
5. Conclusions
Supplementary Materials
Author Contributions
Funding
Institutional Review Board Statement
Informed Consent Statement
Data Availability Statement
Acknowledgments
Conflicts of Interest
References
- Huang, X.H.; Kurata, N.; Wei, X.H.; Wang, Z.-X.; Wang, A.; Zhao, Q.; Zhao, Y.; Liu, K.; Lu, H.; Li, W.; et al. A map of rice genome variation reveals the origin of cultivated rice. Nature 2012, 490, 497–503. [Google Scholar] [CrossRef] [PubMed] [Green Version]
- Victoria, F.C.; Martinez, C. Breeding Rice Cultivars with Durable Blast Resistance in Colombia. In Proceedings of the 4th International Rice Blast Conference, Changsha, China, 9–14 October 2009; pp. 375–383. [Google Scholar]
- Zhuang, J.Y.; Ma, W.B.; Wu, J.L.; Chai, R.Y.; Lu, J.; Fan, Y.Y.; Jin, M.Z.; Leung, H.; Zheng, K.L. Mapping of leaf and neck blast resistance genes with resistance gene analog, RAPD and RFLP in rice. Euphytica 2002, 128, 363–370. [Google Scholar] [CrossRef]
- Chen, C.; Guo, H.; Zhang, X.; Liu, B.; Qin, X.; Feng, R. Blast resistance identification for wild rice from Guangxi and geographical distribution of resistant resources. J. South. Agric. 2017, 48, 1999–2003. [Google Scholar]
- Ballini, E.; Berruyer, R.; Morel, J.-B.; Lebrun, M.-H.; Notteghem, J.-L.; Tharreau, D. Modern elite rice varieties of the ‘Green Revolution’ have retained a large introgression from wild rice around the Pi33 rice blast resistance locus. New Phytol. 2007, 175, 340–350. [Google Scholar] [CrossRef]
- Xiao, N.; Wu, Y.; Pan, C.; Yu, L.; Chen, Y.; Liu, G.; Li, Y.; Zhang, X.; Wang, Z.; Dai, Z.; et al. Improving of Rice Blast Resistances in Japonica by Pyramiding Major R Genes. Front. Plant Sci. 2017, 7, 1918. [Google Scholar] [CrossRef] [PubMed] [Green Version]
- Jiang, H.; Li, Z.; Liu, J.; Shen, Z.; Gao, G.; Zhang, Q.; He, Y. Development and evaluation of improved lines with broad-spectrum resistance to rice blast using nine resistance genes. Rice 2019, 12, 29. [Google Scholar] [CrossRef] [Green Version]
- Lakshmanan, V.; Selvaraj, G.; Bais, H.P. Functional Soil Microbiome: Belowground Solutions to an Aboveground Problem. Plant Physiol. 2014, 166, 689–700. [Google Scholar] [CrossRef] [Green Version]
- Berg, G.; Smalla, K. Plant species and soil type cooperatively shape the structure and function of microbial communities in the rhizosphere. FEMS Microbiol. Ecol. 2009, 68, 1–13. [Google Scholar] [CrossRef] [Green Version]
- Knief, C.; Delmotte, N.; Chaffron, S.; Stark, M.; Innerebner, G.; Wassmann, R.; von Mering, C.; Vorholt, J.A. Metaproteogenomic analysis of microbial communities in the phyllosphere and rhizosphere of rice. ISME J. 2012, 6, 1378–1390. [Google Scholar] [CrossRef] [Green Version]
- Hardoim, P.R.; van Overbeek, L.S.; van Elsas, J.D. Properties of bacterial endophytes and their proposed role in plant growth. Trends Microbiol. 2008, 16, 463–471. [Google Scholar] [CrossRef]
- Dalmastri, C.; Chiarini, L.; Cantale, C.; Bevivino, A.; Tabacchioni, S. Soil type and maize cultivar affect the genetic diversity of maize root-associated Burkholderia cepacia populations. Microb. Ecol. 1999, 38, 273–284. [Google Scholar] [CrossRef] [PubMed]
- Kuklinsky-Sobral, J.; Araujo, W.L.; Mendes, R.; Geraldi, I.O.; Pizzirani-Kleiner, A.A.; Azevedo, J.L. Isolation and characterization of soybean-associated bacteria and their potential for plant growth promotion. Environ. Microbiol. 2004, 6, 1244–1251. [Google Scholar] [CrossRef] [PubMed]
- Shenton, M.; Iwamoto, C.; Kurata, N.; Ikeo, K. Effect of Wild and Cultivated Rice Genotypes on Rhizosphere Bacterial Community Composition. Rice 2016, 9, 42. [Google Scholar] [CrossRef] [PubMed] [Green Version]
- Bulgarelli, D.; Garrido-Oter, R.; Muench, P.C.; Weiman, A.; Droege, J.; Pan, Y.; McHardy, A.C.; Schulze-Lefert, P. Structure and Function of the Bacterial Root Microbiota in Wild and Domesticated Barley. Cell Host Microbe 2015, 17, 392–403. [Google Scholar] [CrossRef] [Green Version]
- Edwards, J.; Johnson, C.; Santos-Medellin, C.; Lurie, E.; Podishetty, N.K.; Bhatnagar, S.; Eisen, J.A.; Sundaresan, V. Structure, variation, and assembly of the root-associated microbiomes of rice. Proc. Natl. Acad. Sci. USA 2015, 112, E911–E920. [Google Scholar] [CrossRef] [Green Version]
- Shi, S.; Chang, J.; Tian, L.; Nasir, F.; Ji, L.; Li, X.; Tian, C. Comparative analysis of the rhizomicrobiome of the wild versus cultivated crop: Insights from rice and soybean. Arch. Microbiol. 2019, 201, 879–888. [Google Scholar] [CrossRef]
- Zhang, J.-w.; Long, Y.; Xue, M.-d.; Xiao, X.-g.; Pei, X.-w. Identification of microRNAs in Response to Drought in Common Wild Rice (Oryza rufipogon Griff.) Shoots and Roots. PLoS ONE 2017, 12, e0170330. [Google Scholar] [CrossRef]
- Mendes, L.W.; Raaijmakers, J.M.; de Hollander, M.; Mendes, R.; Tsai, S.M. Influence of resistance breeding in common bean on rhizosphere microbiome composition and function. ISME J. 2018, 12, 212–224. [Google Scholar] [CrossRef]
- Xu, S.; Tian, L.; Chang, C.; Li, X.; Tian, C. Cultivated rice rhizomicrobiome is more sensitive to environmental shifts than that of wild rice in natural environments. Appl. Soil Ecol. 2019, 140, 68–77. [Google Scholar] [CrossRef]
- Dong, X. Manual for Systematic Identification of Common Bacteria; Science Press: Beijing, China, 2001; p. 373. [Google Scholar]
- Etesami, H.; Hosseini, H.M.; Alikhani, H.A. In planta selection of plant growth promoting endophytic bacteria for rice (Oryza sativa L.). J. Soil Sci. Plant Nutr. 2014, 14, 491–503. [Google Scholar] [CrossRef]
- Xue, X.; Wu, Y. Chlorophyll Content Determination and Its Relationship with SPAD Value in Wheat. Hubei Agric. Sci. 2010, 49, 2701–2702, 2751. [Google Scholar]
- Zhang, Z.A. Experimental Guidance of Plant Physiology; Jilin University Press: Changchun, China, 2016; pp. 161–162. [Google Scholar]
- Saha, S.; Begum, H.H.; Nasrin, S.; Samad, R. Effects of Drought Stress on Pigment and Protein Contents and Antioxidant Enzyme Activities in Five Varieties of Rice (Oryza sativa L). Bangladesh J. Bot. 2020, 49, 997–1002. [Google Scholar] [CrossRef]
- Wang, A.; Huang, H.; Guo, L.; Chen, X.; Liu, J.; Zhang, Y.; Zhang, P. Broad-Spectrum Disease-Resistant Bacillus Velezensis Used in Agricultural Biological Control and Bacillus Velezensis Suspension for Controlling Botrytis, Is Deposited in China General Microbiological Culture Collection Center. CN109022315-A, 9 September 2017. [Google Scholar]
- Cui, W.; Hou, M.; Hou, X.; Long, X.; Yang, R.; Zhan, F.; Zhang, H. Bacillus Velezensis Used as Withered Disease Antagonistic Bacteria on Tomato. CN102286412-A, CN102286412-B, 30 August 2011. [Google Scholar]
- Wei, S.; Wang, H.; Li, J.; Li, S. New Bacillus Velezensis QYQN-3 Strain Useful for Biologically Controlling Rice False Smut. CN109576179-A, 12 December 2018. [Google Scholar]
- Wang, X.; Wang, D.; Sun, G.; Song, G.; Yuan, Y.; Zhang, Y.; Feng, C.; Xia, Z.; Li, X.; Li, G.; et al. New Bacillus Velezensis GY1 Useful in Preparation of Pathogen Inhibitors for Inhibiting Pathogenic Bacteria e.g., Cotton Blight Bacteria, Cucumber Fusarium Wilt Bacteria, Peanut Fusarium, Grape Anthrax Bacteria. CN112391315-A, 20 November 2020. [Google Scholar]
- Yao, J.; Yu, D.; Huang, P.; Lai, B. New Bacillus Velezensis ZZBV-3 Useful for e.g., Controlling and Preventing Plant Diseases, Preferably Strawberry Root Rot, and Inhibiting Sclerotium, Fusarium, Colletotrichum, Penicillium and Aspergillus. CN112877235-A, 28 January 2021. [Google Scholar]
- Zhao, X.; Wu, Y.; Zhao, B.; Li, Y. New Bacillus Velezensis Strain Comprising Bacillus Velezensis SNB55, Useful e.g., for Secreting Indole Acetic Acid for Promoting Seed Germination and Plant Growth, Preventing and Treating Plant Virus Disease and Plant Fungal Diseases. CN109868250-A, 15 April 2019. [Google Scholar]
- Wei, G.; Li, Z.; Bai, X. Strain of Bacillus Velezensis Is Used in Preventing and Controlling Root Rot of Astragalus and Promoting Growth. CN111690572-A, 15 July 2020. [Google Scholar]
- Shen, Z.; Wang, K.; Zhu, J. Preliminary Study on Diagnosis of the Nitrogen Status of Two Rice Varieties Using the Chlorophyll Meter. Bull. Sci. Technol. 2002, 18, 174–176. [Google Scholar]
- Kim, D.S.; Yoon, Y.H.; Shin, J.C.; Kim, J.K.; Kim, S.D. Varietal Difference in Relationship between SPAD Value and Chlorophyll and Nitrogon Concentration in Rice Leaf. Korean J. Crop Sci. 2002, 47, 263–267. [Google Scholar]
- Shu-fang, L.I.; Zhi-jing, Y.U.; Xiu-feng, L.I.N.; Rui, M.A. Advances and Future Trends In Studies on Low Phosphorus Stress of Rice. J. Jilin Agric. Sci. 2009, 34, 37–39, 44. [Google Scholar]
- Abel, S.; Ticconi, C.A.; Delatorre, C.A. Phosphate sensing in higher plants. Physiol. Plant. 2002, 115, 1–8. [Google Scholar] [CrossRef]
- Tian, Z.; Li, J.; Jia, X.; Yang, F.; Wang, Z. Assimilation and Translocation of Dry Matter and Phosphorus in Rice Genotypes Affected by Salt-Alkaline Stress. Sustainability 2016, 8, 568. [Google Scholar] [CrossRef] [Green Version]
- Deng, Q.-W.; Luo, X.-D.; Chen, Y.-L.; Zhou, Y.; Zhang, F.-T.; Hu, B.-L.; Xie, J.-K. Transcriptome analysis of phosphorus stress responsiveness in the seedlings of Dongxiang wild rice (Oryza rufipogon Griff.). Biol. Res. 2018, 51, 7. [Google Scholar] [CrossRef] [Green Version]
- Patel, D.S.; Kirti, B.; Dhiraji, P.P.; Vipulkumar, P.; Suchismita, J.; Ajay, V.N.; Harshadkumar, N.C. Does plant root architecture respond to potassium under water stress? A case from rice seedling root responses. Curr. Sci. 2021, 120, 1050–1056. [Google Scholar] [CrossRef]
- Lin, Q.J.; Kumar, V.; Chu, J.; Li, Z.M.; Wu, X.X.; Dong, H.; Sun, Q.; Xuan, Y.H. CBL-interacting protein kinase 31 regulates rice resistance to blast disease by modulating cellular potassium levels. Biochem. Biophys. Res. Commun. 2021, 563, 23–30. [Google Scholar] [CrossRef]
- Ueno, M.; Kumura, Y.; Ueda, K.; Kihara, J.; Arase, S. Indole derivatives enhance resistance against the rice blast fungus Magnaporthe oryzae. J. Gen. Plant Pathol. 2011, 77, 209–213. [Google Scholar] [CrossRef]
- Pareddy, D.R.; Greyson, R.I. Studies On Sucrose Requirements Of Cultured Maize Tassels. Can. J. Bot.-Rev. Can. De Bot. 1989, 67, 225–229. [Google Scholar] [CrossRef]
- Tremblay, L.; Tremblay, F.M. Carbohydrate Requirements For The Development Of Black Spruce (Picea-Mariana (Mill) Bsp) And Red Spruce (P-Rubens Sarg) Somatic Embryos. Plant Cell Tissue Organ Cult. 1991, 27, 95–103. [Google Scholar] [CrossRef]
- Jing, J.; Jieyun, Z.; Yeyang, F.A.N.; Bo, S. QTL Mapping for Leaf Malondialdehyde Content Associated with Stress Tolerance in Rice. Chin. J. Rice Sci. 2007, 21, 436–438. [Google Scholar] [CrossRef]
- Peng, O.; Ye, C.; Liu, Y.; Li, D.; Liu, S.; Luo, H.; Tie, B. Relationship between SOD Activity and MDA Content in Rice Leaf and Cd Content in Brown Rice under Cd Stress. Asian J. Ecotoxicol. 2019, 14, 233–240. [Google Scholar]
- Zhao, H. Effect of Alkaline Stress on SOD, POD. Activity and MDA Content in Rice Seedling Stage. Heilongjiang Agric. Sci. 2010, 32, 22–23, 27. [Google Scholar]
- Yizong, H.; Wen-qiang, Z.; Li-jun, Z.; Hui-ming, C.A.O. Effects of Si on the Index of Root Activity, MDA Content and Nutritional Elements Uptake of Rice under Salt Stress. Asian J. Ecotoxicol. 2009, 4, 860–866. [Google Scholar]
- Rui, H.; Fu, H.; Jin, Z.; Qiaozhi, L.I.U.; Yan, Z.; Shiqi, Z.; Fuling, P.; Xuemei, Z. Biochemical mechanism of resistance of hybrid rices and their parents to rice blast. Southwest China J. Agric. Sci. 2008, 21, 80–83. [Google Scholar]
- Vaidyanathan, H.; Sivakumar, P.; Chakrabarty, R.; Thomas, G. Scavenging of reactive oxygen species in NaCl-stressed rice (Oryza sativa L.)—Differential response in salt-tolerant and sensitive varieties. Plant Sci. 2003, 165, 1411–1418. [Google Scholar] [CrossRef]
- Mallick, N.; Mohn, F.H. Reactive oxygen species: Response of algal cells. J. Plant Physiol. 2000, 157, 183–193. [Google Scholar] [CrossRef]

| Strain Name | Type of Rice | Classification | Part | Starch Hydrolase | IAA Capability (µg/g) |
|---|---|---|---|---|---|
| 348Y1 | O. punctata | Bacillus velezensis | Shoot | + | − |
| 348Y2 | O. punctata | Bacillus velezensis | Shoot | + | − |
| 348Y3 | O. punctata | Bacillus subtilis | Shoot | + | − |
| 348Y4 | O. punctata | Bacillus amyloliquefaciens | Shoot | + | − |
| 348Y5 | O. punctata | Bacillus licheniformis | Shoot | + | − |
| 348Y6 | O. punctata | Bacillus megaterium | Shoot | − | 34.13 |
| 348Y7 | O. punctata | Fictibacillus nanhaiensis | Shoot | − | − |
| 348G1 | O. punctata | Enterobacter asburiae | Root | + | 47.19 |
| 348G2 | O. punctata | Brevibacterium frigoritolerans | Root | − | − |
| 348G3 | O. punctata | Bacillus anthracis | Root | + | − |
| 348G4 | O. punctata | Enterobacter asburiae | Root | − | − |
| 315Y1 | O. officinalis Wall. ex Watt | Bacillus velezensis | Shoot | + | − |
| 315Y2 | O. officinalis Wall. ex Watt | Enterobacter asburiae | Shoot | + | 29.29 |
| 315Y3 | O. officinalis Wall. ex Watt | Bacillus velezensis | Shoot | + | − |
| 315Y4 | O. officinalis Wall. ex Watt | Bacillus simplex | Shoot | − | 26.23 |
| 315Y5 | O. officinalis Wall. ex Watt | Bacillus thioparans | Shoot | − | − |
| 315Y6 | O. officinalis Wall. ex Watt | Bacillus muralis | Shoot | + | − |
| 315Y7 | O. officinalis Wall. ex Watt | Bacillus velezensis | Shoot | − | − |
| 315G1 | O. officinalis Wall. ex Watt | Bacillus mycoides | Root | + | − |
| 315G2 | O. officinalis Wall. ex Watt | Bacillus velezensis | Root | + | − |
| 315G3 | O. officinalis Wall. ex Watt | Bacillus pseudomycoides | Root | + | − |
| 315G4 | O. officinalis Wall. ex Watt | Bacillus indicus | Root | − | − |
| 315G5 | O. officinalis Wall. ex Watt | Bacillus megaterium | Root | + | 22.52 |
| 315G6 | O. officinalis Wall. ex Watt | Bacillus methylotrophicus | Root | − | − |
| 218Y1 | O. nivara | Lysinibacillus fusiformis | Shoot | + | − |
| 218Y2 | O. nivara | Bacillus oryzaecorticis | Shoot | + | − |
| 218Y3 | O. nivara | Bacillus subtilis | Shoot | + | − |
| 218Y4 | O. nivara | Bacillus arbutinivorans | Shoot | − | − |
| 218G1 | O. nivara | Pantoea septica | Root | − | 21.87 |
| 218G2 | O. nivara | Bacillus indicus | Root | − | − |
| 218G3 | O. nivara | Bacillus cereus | Root | + | − |
| 218G4 | O. nivara | Bacillus aryabhattai | Root | - | 121.55 |
| 218G6 | O. nivara | Bacillus subtilis | Root | + | − |
| 218G7 | O. nivara | Pseudomonas frederiksbergensis | Root | − | − |
| 499Y1 | O. rufipogon Griff. | Bacillus simplex | Shoot | − | − |
| 499Y3 | O. rufipogon Griff. | Bacillus stratosphericus | Shoot | − | − |
| 499Y5 | O. rufipogon Griff. | Bacillus subtilis | Shoot | + | − |
| 499Y6 | O. rufipogon Griff. | Fictibacillus phosphorivorans | Shoot | − | 28.16 |
| 499Y7 | O. rufipogon Griff. | Bacillus firmus | Shoot | − | − |
| 499G2 | O. rufipogon Griff. | Peribacillus simplex | Root | + | 17.68 |
| 499G3 | O. rufipogon Griff. | Bacillus velezensis | Root | + | 24.94 |
| 499G4 | O. rufipogon Griff. | Bacillus megaterium | Root | + | 23.81 |
| 499G5 | O. rufipogon Griff. | Priestia megaterium | Root | + | − |
| 499G6 | O. rufipogon Griff. | Bacillus anthracis | Root | + | − |
| 499G7 | O. rufipogon Griff. | Fictibacillus phosphorivorans | Root | + | 14.61 |
| Strain Name | Antagonism Rate (%) | Error Value | Strain Name | Antagonism Rate (%) | Error Value |
|---|---|---|---|---|---|
| 499G4 | 87.31 a | 0.52 | 315G1 | 84.14 bcd | 1.47 |
| 348Y1 | 85.98 ab | 0.22 | 315G2 | 84.07 cd | 0.71 |
| 315G5 | 85.28 bc | 0.41 | 499G2 | 84.07 cd | 0.83 |
| 315Y3 | 85.27 bc | 0.24 | 315G6 | 84.06 cd | 1.16 |
| 348Y4 | 84.91 bc | 1. 05 | 499Y5 | 83.6 cd | 0.6 |
| 218G6 | 84.78 bc | 1. 39 | 499G3 | 82.53 de | 1.78 |
| 348Y3 | 84.73 bc | 0.28 | 218Y3 | 82.39 de | 0.99 |
| 499Y3 | 84.72 bc | 1. 35 | 315Y7 | 81.85 e | 0.56 |
| 315Y1 | 84.16 bcd | 1. 33 | 218G1 | 55.14 f | 0.42 |
| Potassium-Releasing | |||
| Strains Name | Effect | Strains Name | Effect |
| 218G2 | +++ | 499Y1 | + |
| 499Y7 | +++ | 315Y4 | + |
| 218G7 | +++ | 499Y5 | ++ |
| 348Y7 | ++ | 315G1 | + |
| 315G5 | ++ | 499Y3 | +++ |
| 315G2 | +++ | 499G5 | ++++ |
| 218G1 | +++ | 315Y2 | ++ |
| 348Y6 | + | 499G1 | + |
| 348Y4 | + | 315Y6 | ++++ |
| 499G7 | + | 348G1 | ++ |
| 348Y5 | + | 315Y7 | + |
| 218Y3 | + | 348G2 | + |
| 315Y1 | + | 218G4 | +++ |
| 348Y1 | + | 499G4 | +++ |
| 499G3 | +++ | ||
| Solubilizing Phosphorus | |||
| Strains name | Effect | ||
| 348G1 | + | ||
| 315Y2 | + | ||
| 218G1 | ++ | ||
| 218G7 | + | ||
| 218G4 | + | ||
| Nitrogen Fixation | |||
| Strains name | Effect | ||
| 348G1 | +++ | ||
| 348Y7 | +++ | ||
| 315Y7 | ++ | ||
| 218G1 | +++ | ||
| 315G5 | ++ | ||
| 218G4 | ++ | ||
| 218Y3 | ++ | ||
| 348Y5 | ++ | ||
Publisher’s Note: MDPI stays neutral with regard to jurisdictional claims in published maps and institutional affiliations. |
© 2022 by the authors. Licensee MDPI, Basel, Switzerland. This article is an open access article distributed under the terms and conditions of the Creative Commons Attribution (CC BY) license (https://creativecommons.org/licenses/by/4.0/).
Share and Cite
Yao, Z.; Chen, Y.; Luo, S.; Wang, J.; Zhang, J.; Zhang, J.; Tian, C.; Tian, L. Culturable Screening of Plant Growth-Promoting and Biocontrol Bacteria in the Rhizosphere and Phyllosphere of Wild Rice. Microorganisms 2022, 10, 1468. https://doi.org/10.3390/microorganisms10071468
Yao Z, Chen Y, Luo S, Wang J, Zhang J, Zhang J, Tian C, Tian L. Culturable Screening of Plant Growth-Promoting and Biocontrol Bacteria in the Rhizosphere and Phyllosphere of Wild Rice. Microorganisms. 2022; 10(7):1468. https://doi.org/10.3390/microorganisms10071468
Chicago/Turabian StyleYao, Zongmu, Yalin Chen, Shouyang Luo, Jilin Wang, Jiafan Zhang, Jianfeng Zhang, Chunjie Tian, and Lei Tian. 2022. "Culturable Screening of Plant Growth-Promoting and Biocontrol Bacteria in the Rhizosphere and Phyllosphere of Wild Rice" Microorganisms 10, no. 7: 1468. https://doi.org/10.3390/microorganisms10071468
APA StyleYao, Z., Chen, Y., Luo, S., Wang, J., Zhang, J., Zhang, J., Tian, C., & Tian, L. (2022). Culturable Screening of Plant Growth-Promoting and Biocontrol Bacteria in the Rhizosphere and Phyllosphere of Wild Rice. Microorganisms, 10(7), 1468. https://doi.org/10.3390/microorganisms10071468

